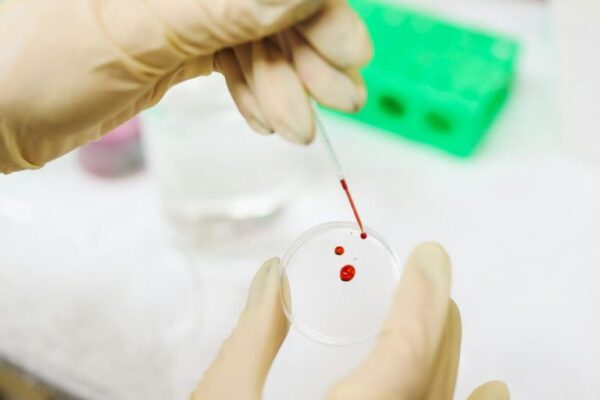
HELLP sindrom kod trudnica

HELLP sindrom kod trudnica je teška komplikacija trudnoće koju karakteriše trijada simptoma:
- hemoliza,
- oštećenje parenhima jetre i
- trombocitopenija.
U većini slučajeva, ovaj sindrom se dijagnostikuje u trećem tromesečju trudnoće, uglavnom u periodu od 33 do 35 nedelja. Može se javiti i u roku od 1-3 dana nakon porođaja, što se javlja u 30% slučajeva.

HELLP sindrom kod trudnica
Grupa visokog rizika uključuje trudnice starije od 35 godina sa teškim somatskim poremećajima. Prevalencija HELLP sindroma varira od 0,1 do 0,6% od ukupnog broja trudnoća.
Klinički se manifestuje kao brzo rastući simptomi, bol u jetri i abdomenu, mučnina, povraćanje, edem, žutilo kože, povećano krvarenje, oštećenje svesti do kome.
Dijagnostikuje se na osnovu opšteg pregleda krvi, proučavanja aktivnosti enzima i hemostaze. Lečenje podrazumeva hitan porođaj, primenu aktivne plazma-zamenjujuće, hepatostabilizujuće i hepatoprotektivne terapije, lekove koji normalizuju hemostazu.
Opšte informacije
Iako se HELLP sindrom poslednjih godina retko primećuje, on komplikuje tešku gestozu u 4-12% slučajeva i, u odsustvu adekvatnog lečenja, karakteriše se visokim stopama smrtnosti majki i odojčadi.
Sindrom kao poseban patološki oblik prvi put je opisan 1954. godine. Naziv poremećaja formiran je od prvih slova termina koji definišu ključne manifestacije bolesti:
H – hemoliza,
EL – povišeni enzimi jetre,
LP – nizak nivo trombocita (trombocitopenija).
Prema zapažanjima, rizična grupa uključuje trudnice svetle puti starije od 35 godina sa teškim somatskim poremećajima (dijagnostikovana preeklampsija ili eklampsija; gojaznost; dijabetes melitus; gestoza). Sa svakom narednom trudnoćom, verovatnoća razvoja bolesti se povećava, posebno ako govorimo o nošenju dva ili više fetusa.

Zašto dolazi do HELLP sindroma kod trudnica
Do danas, etiologija poremećaja nije konačno utvrđena. Specijalisti akušerstva i ginekologije predložili su više od 30 teorija o poreklu ove akutne akušerske patologije. Najverovatnije se razvija kombinacijom faktora, pogoršanih tokom gestoze. Neki autori smatraju trudnoću jednom od opcija za alotransplantaciju, a HELLP sindrom autoimunim procesom.
Među najčešćim uzrocima bolesti
- Imuni i autoimuni poremećaji. U krvi pacijentkinja primećuje se depresija B- i T-limfocita, određuju se antitela na trombocite i vaskularni endotel. Odnos u paru prostaciklin/tromboksan je smanjen. Ponekad bolest komplikuje tok druge autoimune patologije – antifosfolipidnog sindroma(Huges Sy).
- Genetske anomalije. Osnova za razvoj sindroma može biti kongenitalna insuficijencija enzimskih sistema jetre, što povećava osetljivost hepatocita na dejstvo štetnih faktora koji se javljaju tokom autoimunog odgovora. Jedan broj trudnica takođe ima kongenitalne poremećaje sistema koagulacije.
- Nekontrolisana upotreba određenih lekova. Verovatnoća razvoja patologije povećava se upotrebom farmakoloških lekova koji imaju hepatotoksični efekat. Pre svega, govorimo o tetraciklinu i hloramfenikolu, čiji se štetni efekat povećava sa nezrelošću enzimskih sistema.
Patogeneza
Okidač za razvoj HELLP sindroma je smanjenje proizvodnje prostaciklina na pozadini autoimune reakcije koja nastaje kao rezultat dejstva antitela na krvne ćelije i endotel. To dovodi do mikroangiopatskih promena u unutrašnjoj oblozi krvnih sudova i oslobađanja placentnog tromboplastina, koji ulazi u krvotok majke. Paralelno sa oštećenjem endotela, javlja se vaskularni spazam, što provocira placentnu ishemiju.
Sledeća faza u patogenezi HELLP sindroma je mehaničko i hipoksično uništavanje eritrocita, koji prolaze kroz spasmodični vaskularni korito i aktivno ih napadaju antitela. Na pozadini hemolize, povećava se adhezija i agregacija trombocita, njihov ukupni nivo se smanjuje, krv se zgušnjava, javlja se višestruka mikrotromboza sa naknadnom fibrinolizom, razvija se DIK sindrom. Oštećena perfuzija u jetri dovodi do stvaranja hepatoze sa nekrozom parenhima, stvaranja subkapsularnih hematoma i povećanja nivoa enzima u krvi. Zbog vaskularnog spazma, arterijski pritisak se povećava. Kako su i drugi sistemi uključeni u patološki proces, povećavaju se znaci višestruke organske insuficijencije.
Klasifikacija HELLP sindroma
Ne postoji jedinstvena sistematizacija oblika HELLP sindroma. Neki strani autori predlažu da se prilikom određivanja varijante patološkog stanja uzmu u obzir podaci laboratorijskih testova. Jedna od postojećih klasifikacija razlikuje tri kategorije laboratorijskih parametara koji odgovaraju skrivenim, sumnjivim i očiglednim znacima intravaskularne koagulacije. Preciznija opcija zasniva se na određivanju koncentracije trombocita. Prema ovom kriterijumu, razlikuju se tri klase sindroma:
- klasa 1. Nivo trombocitopenije je manji od 50×10 9/l. Kliničku sliku karakteriše težak tok i ozbiljna prognoza.
- klasa 2. Broj trombocita u krvi je od 50 do 100×10 9/l. Tok sindroma i prognoza su povoljniji.
- Klasa 3. Primećuju se umerene manifestacije trombocitopenije (od 100 do 150×10 9 /l). Primećuju se prvi klinički znaci.
Simptomi HELLP sindroma kod trudnica
Početne manifestacije bolesti su nespecifične. Trudnica ili porodilja se žali na bol u epigastrijumu, desnom hipohondrijumu i trbušnoj duplji, glavobolju, vrtoglavicu, osećaj težine u glavi, bolne senzacije u mišićima vrata i ramenog pojasa. Povećavaju se slabost i brzi zamor, pogoršava se vid, javljaju se mučnina i povraćanje , nadimanje, otoci, uglavnom u licu i gornjim ekstremitetima, i visok krvni pritisak.
Klinička slika ima tendenciju brzog napredovanja, pri čemu se intenzitet simptoma često spontano menja. Često se manifestacije bolesti pogoršavaju noću, a smanjuju tokom dana. Kako se patološki proces razvija, gore navedenim simptomima mogu se pridružiti konfuzija, zamućen vid i letargija. U teškim slučajevima HELLP sindroma, krv može biti prisutna u povraćanju, kao i napadi. U terminalnim fazama razvija se komatozno stanje.
Komplikacije
HELLP sindrom karakteriše višestruka disfunkcija organa sa dekompenzacijom glavnih vitalnih funkcija tela. U skoro polovini slučajeva, bolest je komplikovana DIK sindromom, svaki treći pacijent ima znake akutne bubrežne insuficijencije, a svaki deseti pacijent ima cerebralni ili plućni edem. Neki pacijenti razvijaju eksudativni pleuritis i sindrom plućnog distresa.
U postporođajnom periodu moguće je obilno krvarenje iz materice sa hemoragičnim šokom. U retkim slučajevima, žene sa HELLP sindromom doživljavaju odvajanje ćelijskog tkiva, što dovodi do hemoragičnog moždanog udara. Kod 1,8% pacijenata otkrivaju se subkapsularni hematomi jetre, čija ruptura obično dovodi do masivnog intraabdominalnog krvarenja i smrti trudnice ili porodilje.
HELLP sindrom je opasan ne samo za majku, već i za dete. Ako se patologija razvije kod trudnice, povećava se verovatnoća prevremenog porođaja ili abrupcije placente sa koagulopatskim krvarenjem. U 7,4-34,0% slučajeva, fetus umire u materici. Skoro trećina novorođenčadi ima trombocitopeniju, što dovodi do krvarenja u moždanom tkivu i posledičnih neuroloških poremećaja. Neka deca se rađaju u stanju asfiksije ili sa respiratornim distresom. Ozbiljna, iako retka, komplikacija bolesti je crevna nekroza, koja se otkriva kod 6,2% novorođenčadi.

Dijagnostika
Sumnja na razvoj HELLP sindroma kod pacijenta je osnova za hitne laboratorijske testove kojima se verifikuje oštećenje sistema hemostaze i parenhima jetre. Pored toga, obezbeđuje se praćenje glavnih vitalnih parametara (brzina disanja, pulsna temperatura, krvni pritisak, koji je povišen kod 85% pacijenata).
Sledeće vrste pregleda su najvrednije u dijagnostičkom smislu:
- Opšta analiza krvi.Utvrđuje se smanjenje broja eritrocita i njihova polihromazija, deformisana ili uništena crvena krvna zrnca. Jedan od dijagnostički pouzdanih kriterijuma je trombocitopenija manja od 100×10 9 /l. Broj leukocita i limfocita je obično nepromenjen, primećuje se izvesno smanjenje sedimentacije eritrocita (SE). Nivo hemoglobina pada.
- Testovi funkcije jetre. Otkriveni su poremećaji enzimskog sistema tipični za oštećenje jetre: aktivnost aminotransferaza (AST, ALT) je povećana 12-15 puta (do 500 U/l). Aktivnost alkalne fosfataze se povećava 3 puta ili više. Nivo bilirubina u krvi prelazi 20 μmol/l. Koncentracije proteina i haptoglobina su smanjene.
- Evaluacija sistema hemostaze. Karakteristični su laboratorijski znaci koagulopatije konzumacije – sadržaj faktora koagulacije sintetizovanih u jetri uz učešće vitamina K se smanjuje. Nivo antitrombina III je smanjen. Poremećaj koagulacije krvi je takođe indikovan povećanjem trombinskog vremena, smanjenjem APTT-a i koncentracije fibrinogena.
Treba napomenuti da tipični laboratorijski znaci HELP sindroma mogu neravnomerno odstupati od normativnih indikatora, u takvim slučajevima govore o varijantama bolesti – ELLP sindromu (nema hemolize eritrocita) i HEL sindromu (sadržaj trombocita nije poremećen). Za ekspresnu procenu stanja jetre sprovodi se njen ultrazvučni pregled.
Pošto teški oblici bolesti narušavaju funkciju bubrega, smanjenje dnevne količine urina, pojava proteinurije i povećanje sadržaja azotnih supstanci u krvi (urea, kreatinin) smatraju se prognostički nepovoljnim faktorima. Uzimajući u obzir patogenezu bolesti, preporučuju se EKG, ultrazvuk bubrega i pregled fundusa. U prenatalnom periodu se izvode CTG, ultrazvuk materice i Dopler radi praćenja stanja fetusa, hemodinamike fetusa i majke.
Diferencijalna dijagnostika
HELLP sindrom se mora razlikovati od teške gestoze, masne hepatoze trudnoće, virusnog i lekovima izazvanog hepatitisa, nasledne trombocitopenične purpure i hemolitičko-uremičkog sindroma.
Diferencijalna dijagnostika se takođe sprovodi sa
- Intrahepatičnom holestazom,
- Dubin-Džonsonovim sindromomi Bad-Kijarijevim sindromom,
- sistemskim eritematoznim lupusom,
- citomegalovirusnom infekcijom,
- infektivnom mononukleozomi drugim patološkim stanjima.
S obzirom na ozbiljnost prognoze bolesti, nedavno je primećena njena hiperdijagnoza. U složenim kliničkim slučajevima, u dijagnostičku pretragu uključeni su hepatolog, neurolog, oftalmolog, specijalista za zarazne bolesti i drugi specijalisti.

Lečenje HELLP sindroma
Medicinska taktika pri otkrivanju bolesti kod trudnice usmerena je na prekid trudnoće u roku od 24 sata od trenutka dijagnoze.
Pacijentkinjama sa zrelim grlićem materice preporučuje se porođaj kroz prirodni porođajni kanal, ali češće se izvodi hitan carski rez pod endotrahealnom anestezijom primenom nehepatotoksičnih anestetika i produžene veštačke ventilacije. U fazi intenzivne preoperativne pripreme, zbog uvođenja sveže zamrznute plazme, kristaloidnih rastvora, glukokortikoida, inhibitora fibrinolize, stanje žene se maksimalno stabilizuje, a ako je moguće, kompenzuju se poremećeni višeorganski poremećaji.
Kompleksna terapija lekovima usmerena na eliminisanje angiopatija, mikrotromboza, hemolize, uticaj na različite karike patogeneze, obnavljanje funkcije jetre, drugih organa i sistema, aktivno se nastavlja u postoperativnom periodu.
Za lečenje sindroma, sprečavanje ili eliminisanje njegovih mogućih posledica, preporučuje se sledeće:
- Infuziona i terapija zamene krvi. Uvođenje krvne plazme i njenih supstituta, trombokoncentrata, složenih fizioloških rastvora omogućava nadoknadu uništenih formiranih elemenata i nedostatka tečnosti u intravaskularnom koritu. Dodatni efekat takve terapije je poboljšanje reoloških parametara i stabilizacija hemodinamike.
- Hepatostabilizujući i hepatoprotektivni lekovi. Za stabilizaciju citolize jetrepropisuje se parenteralna primena glukokortikoida. Upotreba hepatoprotektora ima za cilj poboljšanje funkcionisanja hepatocita, zaštitu od toksičnih metabolita i stimulaciju obnove uništenih ćelijskih struktura.
- Sredstva za normalizaciju hemostaze. Da bi se poboljšao sistem koagulacije krvi, smanjile manifestacije hemolize i sprečila mikrotromboza, koriste se niskomolekularni heparini, drugi dezagreganti i antikoagulansi, kao i lekovi sa vazoaktivnim dejstvom. Upotreba inhibitora proteaze je efikasna.
Uzimajući u obzir hemodinamske parametre, pacijenti sa HELLP sindromom podvrgavaju se individualizovanoj hipotenzivnoj terapiji dopunjenoj antispazmodicima. Da bi se sprečile moguće infektivne komplikacije, koriste se antibiotici, sa izuzetkom aminoglikozida, koji imaju hepato- i nefrotoksični efekat. Nootropni i cerebroprotektivni lekovi, vitaminski i mineralni kompleksi se propisuju prema indikacijama. Ukoliko se pojave manifestacije akutne bubrežne insuficijencije, sprovode se plazmafereza i hemodijaliza u zavisnosti od težine poremećaja .
Prognoza i prevencija
Prognoza za HELLP sindrom je uvek ozbiljna. U prošlosti je stopa smrtnosti od ove bolesti dostigla 75%. Trenutno, zahvaljujući blagovremenoj dijagnostici i patogenetskim metodama terapije, smrtnost majki je smanjena na 25%.
U preventivne svrhe, ženama koje ponovo rađaju sa hroničnim somatskim bolestima preporučuje se da se rano prijave u žensku konsultaciju i da se stalno podvrgavaju nadzoru akušera-ginekologa. Ukoliko se otkriju znaci gestoze, važno je pažljivo pratiti uputstva lekara, normalizovati ishranu, održavati režim spavanja i odmora. Brzo pogoršanje stanja trudnice sa razvojem simptoma teške eklampsije i preeklampsije je indikacija za hitnu hospitalizaciju u akušerskoj bolnici.

















